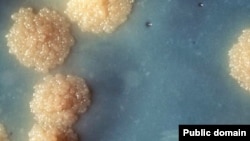

Сегодня ученые пришли к выводу, что главный путь усложнения организмов – это не случайные мутации, а добавление и комбинирование целых блоков генов. Блочный принцип устройства геномов предопределяет эволюционное развитие на несколько шагов вперед. Геном хранит свою программу развития.
Ученые убедились, что мутации, то есть тот материал, с которым работает естественный отбор, не могут происходить в любом месте хромосомы. Неслучайность мутаций заставляет делить естественный отбор делить на две фазы. Первую контролируют молекулярные механизмы, то есть сами гены и белки, а уже вторую определяют внешние условия.
Для изучения первой фазы естественного отбора исключительно удобным объектом являются микроорганизмы. У них компактный геном, его относительно легко прочитать, они легко мутируют и очень быстро размножаются. Поэтому изучение механизмов эволюционного развития и в особенности ее первой фазы сейчас во многом перешло из области исследования ископаемых животных и растений в область микробиологических исследований.
Член-корреспондент Академии Медицинских наук профессор института микробиологии и иммунологии им. Гамалеи Георгий Смирнов рассказывает о современном представлении о закономерностях эволюции живого мира.
– Каковы основные изменения в теории эволюции, которые произошли со времен Чарльза Дарвина?
– Теория Дарвина заложила основы понимания эволюции, она описала естественный отбор. Он действует, он работает в окружающей среде, все это, безусловно, есть. Но было бы наивно думать, что только этим все ограничивается. Мы прекрасно понимаем, что мы не можем объяснить с помощью тех данным, которыми располагал Дарвин, все, что мы наблюдаем сейчас. Грош цена была бы такой науке, если бы за сто лет развития она ничего нового не обнаружила. Но она обнаружила такую массу явлений, о которых ни Дарвин, ни его последователи не могли даже подозревать. Ведь тогда не было ничего известно о ДНК, не было известно ничего о генах. Тогда термин «мутация» уже употреблялся, но очень условно и абстрактно – никто не знал, что это такое. Совсем недавно благодаря успехам генетики, прежде всего генетики микроорганизмов, а в последнее десятилетие успехам молекулярной биологии, удалось прочитать геномные тексты. Все слышали о том, что прочитан геном человека, точно так же прочитаны геномы и многих микроорганизмов, в том числе тех, которые вызывают те или иные заболевания.
– Сколько приблизительно нуклеотидов, то есть «букв», содержит ДНК микроорганизма?
– У стандартного микроба их около четырех миллионов. Например, столько нуклеотидов у возбудителя туберкулеза (Mycobacterium tuberculosis – палочки Коха). А у его ближайшего родственника возбудителя проказы, примерно на миллион меньше. Причем, если говорить о генах, то если в первом случае этих генов – четыре тысячи с лишним, то во втором случае почти на две тысячи меньше. Но это наблюдается не только у патогенных организмов, это наблюдается и у симбионтов. Симбионты – это тоже бактерии, но они не вызывают заболевания, а живут в симбиозе с многоклеточными организмами. В частности, симбионт мухи-цеце очень ей полезен, без него муха-цеце не могла бы размножаться.
Процесс размножения мухи-цеце имеет не только академический интерес. Муха-цеце является распространителем другого организма – трипаносома бруция, который вызывает сонную болезнь. Очень актуально для африканских стран лишить муху-цеце возможности репродукции, а для этого ее нужно лишить симбионтов.
У бактерий симбионтов геном еще меньше, чем у вредоносных микроорганизмов. Скажем, у того же симбионта мухи-цеце около 600 генов, точнее – 611. У симбионта тлей – около пятисот генов. Но рекордно малым геномом обладает симбиотическая бактерия Carsonella ruddii обитающая в кишечнике псиллиды (листоблошки). Это насекомое, похожее на маленькую цикаду. У Carsonella ruddii всего 182 гена, более короткий геном на сегодня неизвестен.
Оказывается, симбионты утратили все гены, которые в условиях их существования не нужны. Постольку поскольку все, что необходимо такой симбионт получает от многоклеточного организма, в котором он живет.
– Симбиотические бактерии паразитируют на тех организмах, в которых они живут?
– Конечно. То же самое можно сказать и о патогенных организмах. Они могут восполнять недостатки своего метаболизма за счет хозяина.
– Можно сказать, что утраченные гены стали ненужными в условиях среды обитания?
– Это общепринятая концепция. Сегодня большинство ученых считает, что гены, которые были утрачены, утрачены были потому, что они поддерживаться естественным отбором.
Я как раз думаю, что эта точка зрения некорректна. Во-первых, ближайшие родственники этих самых организмов с редуцированными геномами, оставаясь, например, патогенными паразитами, свои гены не утрачивали, а сохранили в полном объеме. Во-вторых, оказалось, что процесс утраты генов присущ не только паразитирующих микроорганизмам, но и свободно живущим. Так в фитопланктоне океана есть такая цианобактерия, в ней обнаружен процесс редукции генома, который идет до сих пор.
Она составляет большую часть биомассы фитопланктона океана поверхностных слоев. То есть она живет совершенно свободно, ни на ком не паразитирует, но тем не менее утрачивает гены. Более того, процессы редукции или компактизации геномов отмечены и у насекомых, и у растений. Они не паразиты, а свободно живущие организмы, тем не менее, там это тоже имеет место.
– Геном имеет свою собственную программу развития?
– Да, так можно сказать. Эта программа не является жестко детерминированной. Она должна меняться, потому что каждое изменение приводит к изменению структуры генома. Если меняется структура генома, меняется и программа его эволюционных изменений. Организм сам определяет направление своего эволюционного развития, и программа изменений закодирована внутри самого организма.
Очень важно подчеркнуть, что с помощью мутации нельзя создать новый ген, а с помощью рекомбинации, то есть внедрения сегмента ДНК одного объекта в геном другого, может быть привнесен новый ген. Здесь есть совершенно чудесные вещи. Иногда микроорганизм-симбионт может унаследовать ген своего многоклеточного хозяина, который ему совершенно не нужен.
– Можно сказать, что геном строится, как блочный дом, причем по некоторому плану?
– Геномы современных организмов действительно состоят из крупных блоков, которые часто имеют самое разнообразное происхождение. Действительно, эволюция идет по пути создания геномов из блоков. Причем, если использовать предложенную аналогию с домом, можно заметить, что дом всегда моложе, чем блоки, из которых он построен. В свое время природа отобрала те или иные блоки. Очень часто гены, объединяемые одной функцией, находятся вместе. Такое объединение генов называется геномным островом. Если этот остров отвечает, допустим, за болезнетворные свойства, он называется островом патогенности. И эти геномные блоки, видимо, собирались, когда сегменты ДНК встраивались в определенные предпочтительные сайты (места) другой ДНК. Это процесс универсальный, всеобщий.
В блоках гены теряются, в блоках они приобретаются и в блоках они заменяются. Это – потенциальная возможность приспособиться к новой экологической нише. Можно назвать этот процесс пред-адаптацией – предвидением возможных перемен.
Конечно, ни о какой полной предопределенности речь не идет. Но нет и полной случайности, как считалось раньше.